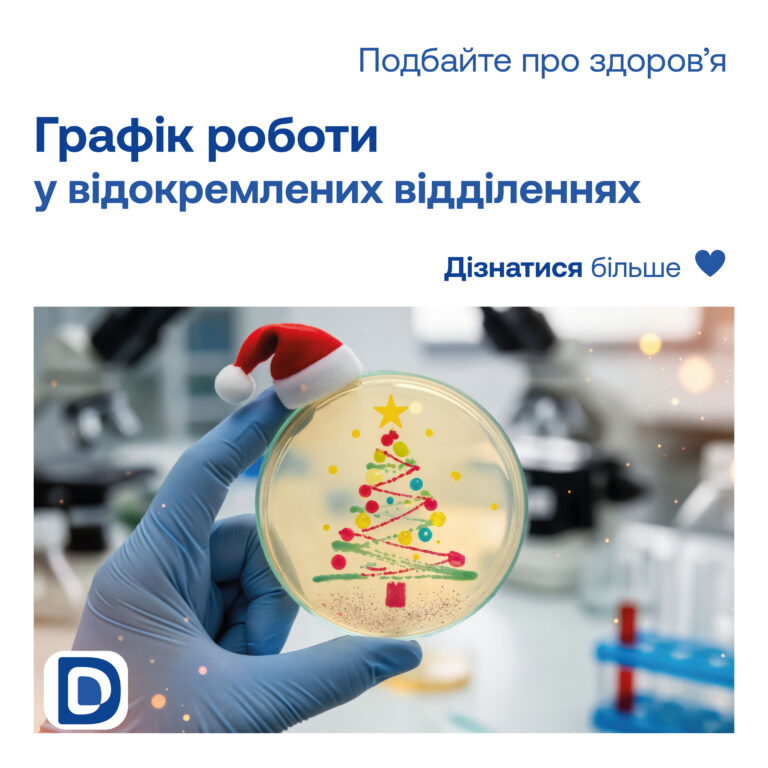

Шановні пацієнти!
Звертаємо вашу увагу на зміни в графіку роботи відділень лабораторії «Діагностика Україна»:
25 грудня 2025 року (четвер)
31 грудня 2025 року (середа)
Працюють лише відокремлені відділення в місті Київ за адресами:
- пр-т Любомира Гузара, 3, корпус 8
(вхід з вул. Стражеска) - просп. Повітряних Сил, 9
Київська клінічна лікарня на залізничному транспорті №2
(поліклініка), 2-й поверх, кабінет 222

08:00 – 11:00
1 січня 2026 року (четвер)
📞 Деталі за телефоном: 0 800 60 00 40 (безкоштовні дзвінки з фіксованих та мобільних операторів зв’язку України)
Просимо заздалегідь планувати візит до відокремлених відділень європейської медичної лабораторії “Діагностика Україна”.
Дякуємо за розуміння та бажаємо вам світлих і здорових свят!